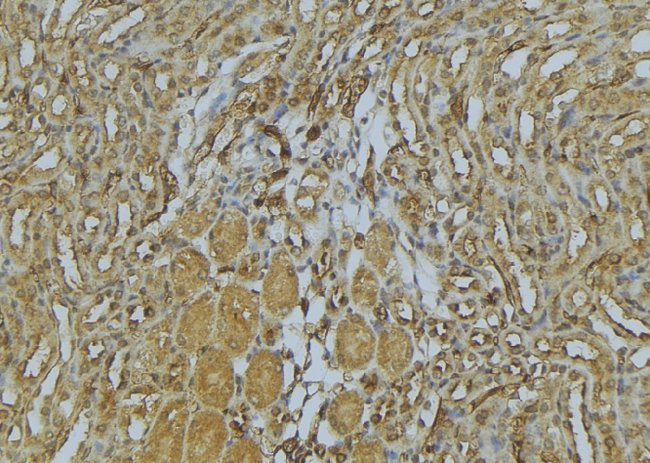
Myosin 4 Antibody in Immunohistochemistry (Paraffin) (IHC (P))

Search
Invitrogen
Myosin 4 Polyclonal Antibody
{{$productOrderCtrl.translations['antibody.pdp.commerceCard.promotion.promotions']}}
{{$productOrderCtrl.translations['antibody.pdp.commerceCard.promotion.viewpromo']}}
{{$productOrderCtrl.translations['antibody.pdp.commerceCard.promotion.promocode']}}: {{promo.promoCode}} {{promo.promoTitle}} {{promo.promoDescription}}. {{$productOrderCtrl.translations['antibody.pdp.commerceCard.promotion.learnmore']}}
Additional Information:
{{banner.description}}
图: 1 / 3
Myosin 4 Antibody (PA5-100045) in IHC (P)
Immunohistochemistry analysis of paraffin-embedded Myosin 4 in mouse kidney tissue. Antigen retrieval was performed using citrate buffer. Samples were blocked with blocking buffer (1.5 hr, 22°C), incubated with Myosin 4 polyclonal antibody (Product # PA5-100045) using a dilution of 1:100 (1.5 hr, 22°C), followed by HRP conjugated goat anti-rabbit.



产品信息
PA5-100045
产品规格
宿主/亚型
Rabbit
/ IgG
分类
Polyclonal
类型
Antibody
抗原
A synthesized peptide derived from human MYH4(Accession Q9Y623), corresponding to amino acid residues V1456-L1485.
偶联物
Unconjugated
Unconjugated
Unconjugated
形式
Liquid
浓度
1 mg/mL
规格
100 µg
保存条件
-20°C
运输条件
Wet ice
RRID
靶标信息
Target protein includes a fast myosin isoform expressed in skeletal muscle and has function involved in Muscle contraction.
仅用于科研。不用于诊断过程。未经明确授权不得转售。
篇参考文献 (0)
您是否在文献中引用过该产品?请点击下方按钮邮件告知我们。